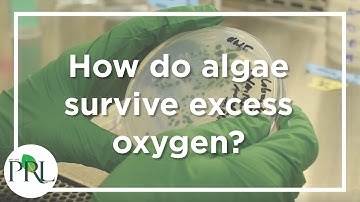
Kramer lab: How do algae survive excess oxygen?

⬇ DOWNLOAD NOW
Kalau muncul iklan pop-up, tutup lalu klik tombol kembali
Download lagu Mrs Murdock explains how to calculate Algae Lab Data secara gratis hanya untuk keperluan promosi. Dukung artis favorit kamu dengan membeli musik original di iTunes atau platform resmi lainnya.
 Mrs. Murdock explains the Flowchart of Anaerobic pathways
Mrs. Murdock explains the Flowchart of Anaerobic pathways
 Introducing some algae measurement
Introducing some algae measurement
Kramer lab: How do algae survive excess oxygen?
Kramer lab: How do algae survive excess oxygen?
 ADA: Correlation Plots For Microalgae Data Analysis
ADA: Correlation Plots For Microalgae Data Analysis
 MV CYANO 2024 Data - presented 01May2025
MV CYANO 2024 Data - presented 01May2025
 Algae Harvest part 1
Algae Harvest part 1
 Algal Scientific Explains Why Michigan? | MEDC
Algal Scientific Explains Why Michigan? | MEDC
 Protecting #Shellfish #Farms with the ShellEye Project: What #Satellite Data Can Do for #Aquaculture
Protecting #Shellfish #Farms with the ShellEye Project: What #Satellite Data Can Do for #Aquaculture